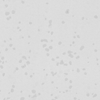
Storm Gray

Knight Quartz Flooring - 耐德石英地板-全球领先的石英地板制造商
耐德石英地板产品简介
耐德石英地板产品丰富、花样繁多、通过提供无穷的创意来美化您的生活和工作环境。
耐德石英地板70%的成分为天然石英砂,与柔韧性极强的乙烯充分混合作为最基本的原料。产品具有同质透心的特性。用于生产耐德石英地板的石英颗粒是精细的水磨晶体,大大增加了地板的牢固性。
同质透心的性能保证产品的颜色、花纹能保持始终如一。高含量的石英砂成分令产品经久耐磨,增加了产品的使用寿命,同时大大节约了成本。
高度耐磨性,丰富的花样品种,低膨胀性,高性价比,令耐德石英地板在众多的竞争对手中脱颖而出,成为弹性地材的最佳解决方案。
了解更多产品信息,请看以下各系列产品的详细说明。

石杰
常规尺寸 300X300mm 600X600mm
常规尺寸 300X300mm 600X600mm
突破性的无方向性式样的地板终于投放市场。
我们运用精细的工艺,生产出来的这一新系列更符合目前与未来趋势的产品。完美的设计以及花纹处理使得产品更耐日常污染。独特的产品质量和设计,令石杰系列符合任何环境的要求。我们这一崭新的系列提供您对地面设计的无穷的想象,同时符合您对弹性地板特性的要求。UV涂层的添加使地板抗划痕性能大大提高。
 |
 |
 |
 |
 |
 |
冬白 010 |
光白 014 |
沙白 020 |
宇黑 080 |
阳米 |
漠啡 125 |
|
 |
 |
 |
 |
 |
风灰 230 |
迷灰 280 |
晨青 735 |
幻蓝 870 |
石白 060 |
星黑 092 |
 |
 |
 |
|||
点灰 220 |
春绿 746 |
海蓝 816 |
Install / Maintenance Guidelines
安装/维护指南
订购请咨询86-21-63759388
矿仕
常规尺寸 300X300mm 600X600mm
从来没有一种地面材料有这样精彩的设计和视觉效果。
矿仕系列提供新设计的式样和色彩来反映当今和未来的流行趋势。最新的设计增加多色彩的条纹另它卓尔不群,亦可以帮助隐藏日常交通量所产生的痕迹,矿仕系列继续成为设计师们在任何使用场地上的首选地面材料。UV涂层的添加使地板抗划痕性能大大提高。
Install / Maintenance Guidelines
安装/维护指南
订购请咨询86-21-63759388
常规尺寸 300X300mm 600X600mm
从来没有一种地面材料有这样精彩的设计和视觉效果。
矿仕系列提供新设计的式样和色彩来反映当今和未来的流行趋势。最新的设计增加多色彩的条纹另它卓尔不群,亦可以帮助隐藏日常交通量所产生的痕迹,矿仕系列继续成为设计师们在任何使用场地上的首选地面材料。UV涂层的添加使地板抗划痕性能大大提高。
 |
 |
 |
 |
 |
 |
| 冰白 006-07 |
彩白 012-07 |
皓米 022-07 |
礼黑 075-07 |
彩米 115-07 |
意啡 144-07 |
 |
 |
 |
 |
 |
 |
| 影灰 214-07 |
方红 308-07 |
蜜黄 608-07 |
轻啡 646-07 |
亮黄 690-07 |
林绿 712-07 |
 |
 |
 |
 |
||
| 荷绿 724-07 |
雨蓝 812-07 |
皇蓝 814-07 |
海绿 842-07 |
Install / Maintenance Guidelines
安装/维护指南
订购请咨询86-21-63759388
丽杰
常规尺寸 300X300mm 600X600mm
丽杰石英砂地板,已在市场使用超过50年。它卓越的耐磨和柔韧性,令他在市场上成为设计师的地材首选材料。
常规尺寸 300X300mm 600X600mm
丽杰石英砂地板,已在市场使用超过50年。它卓越的耐磨和柔韧性,令他在市场上成为设计师的地材首选材料。
 |
 |
 |
 |
 |
 |
| 元白 018-07 |
银灰 026-07 |
雾白 047-07 |
露白 048-07 |
浅黑 084-07 |
浅褐 128-07 |
 |
 |
 |
 |
 |
 |
| 船灰 284-07 |
砖红 320-07 |
油黄 622-07 |
杨啡 630-07 |
杨绿 740-07 |
蕚绿 760-07 |
 |
 |
 |
 |
||
| 靛蓝 810-07 |
灰蓝 820-07 |
书蓝 832-07 |
深紫 920-07 |
Install / Maintenance Guidelines
安装/维护指南
订购请咨询86-21-63759388
